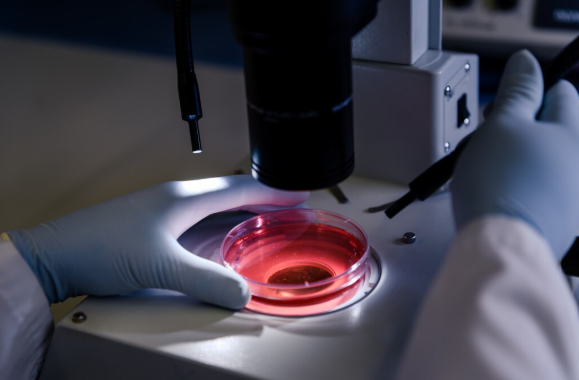
Công nghệ hình ảnh siêu nhạy giúp phát hiện ung thư sớm - Ảnh 1.

Các nhà khoa học vừa phát triển hệ thống hình ảnh siêu nhạy mở hướng sàng lọc ung thư nhanh, ít xâm lấn – Ảnh minh họa: FREEPIK
Các nhà khoa học vừa phát triển một hệ thống hình ảnh nhỏ gọn, cho phép phân biệt chính xác mô ung thư và tế bào khỏe mạnh bằng cách phát hiện những tín hiệu ánh sáng cực kỳ yếu. Công nghệ này được kỳ vọng sẽ đẩy nhanh quá trình sàng lọc, giúp phát hiện khối u sớm hơn và giảm thiểu tình trạng chậm trễ trong chẩn đoán.
Nghiên cứu công bố trên tạp chí Optica giới thiệu một hướng tiếp cận mới nhằm đưa các công cụ hình ảnh phân tử tiên tiến ra khỏi phòng thí nghiệm, tiến gần hơn tới ứng dụng lâm sàng thực tế.
Hệ thống được thiết kế để ghi nhận tín hiệu từ các hạt nano tán xạ Raman tăng cường bề mặt (SERS) – những hạt nano được chế tạo để bám vào các dấu hiệu sinh học của khối u. Khi đưa vào mẫu mô hoặc vùng cần kiểm tra, thiết bị sẽ đọc tín hiệu Raman phát ra và tự động làm nổi bật các khu vực có khả năng chứa tế bào ung thư.
Theo trưởng nhóm nghiên cứu Zhen Qiu, thuộc Viện Khoa học Kỹ thuật và Sức khỏe Định lượng (IQ), Đại học Bang Michigan (Mỹ), các phương pháp chẩn đoán truyền thống thường mất nhiều thời gian do phải nhuộm mẫu và phân tích bệnh học.
Dù chưa thể thay thế hoàn toàn giải phẫu bệnh, hệ thống mới có thể đóng vai trò như một công cụ sàng lọc nhanh, hỗ trợ bác sĩ trong quá trình ra quyết định.
Nhóm nghiên cứu cho biết hệ thống này có thể phát hiện các tín hiệu Raman yếu hơn khoảng bốn lần so với ngưỡng mà các thiết bị thương mại tương đương hiện nay đo được. Độ nhạy vượt trội này đạt được nhờ sự kết hợp giữa nguồn laser quét và đầu dò đơn photon dây nano siêu dẫn (SNSPD) – một cảm biến có khả năng bắt được từng hạt ánh sáng riêng lẻ ở tốc độ cao, đồng thời duy trì mức nhiễu nền rất thấp.
Trong quá trình thử nghiệm, các nhà khoa học sử dụng hạt nano SERS được phủ axit hyaluronan, cho phép chúng liên kết với CD44 – loại protein bề mặt phổ biến trên nhiều tế bào khối u. Kết quả thử nghiệm trên tế bào ung thư vú nuôi cấy và trên chuột cho thấy tín hiệu tập trung mạnh tại các mô bệnh, trong khi mô khỏe mạnh hầu như không xuất hiện tín hiệu nền.
Theo đánh giá của nhóm nghiên cứu, công nghệ này có tiềm năng được phát triển thành các thiết bị cầm tay hoặc thiết bị sử dụng trực tiếp trong phẫu thuật. Điều đó có thể giúp bác sĩ phát hiện ung thư ở giai đoạn sớm hơn, nâng cao độ chính xác khi lấy mẫu sinh thiết và theo dõi tiến triển bệnh thông qua các phương pháp ít xâm lấn hơn.
Đọc tiếp
Về trang Chủ đề
Nguồn: https://tuoitre.vn/cong-nghe-hinh-anh-sieu-nhay-giup-phat-hien-ung-thu-som-20251223110550482.htm

